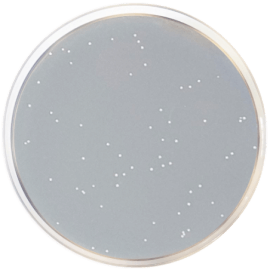
main product photo

Close
R2A AGAR (Eur. Pharma.) 500 grams/bottle
SKU
CDL/1071
Brand
CONDALAB
Pre-order (Deliver in 8 to 12 weeks)
R2A AGAR was developed by Reasoner and Geldreich for bacteriological plate counts of treated potable water, being able to recover the stressed chlorine-treated bacteria. Nutritionally rich mediums suppress these slow growing bacteria, whereas a low nutrient medium, such as R2A Agar, in combination with a lower incubation temperature and longer incubation time, stimulates the growth of stressed and chlorine-tolerant bacteria.
Proteose peptone and Casein Hydrolysate provide nitrogen, vitamins, minerals and amino acids essential for growth. Yeast extract is the source of vitamins, particularly of the B-group. Dextrose is a source of fermentable carbohydrate as an energy source; Starch absorbs toxic metabolic byproducts and thereby aids the recovery of injured organisms. Sodium pyruvate increases the recovery of stressed cells. Magnesium sulfate provides divalent cations and sulfate. Dipotassium phosphate is used to balance the pH and provide phosphate. Bacteriological agar is solidifying base.
R2A Agar is recommended in Standard Methods for the Examination of Water and Wastewater for pour plate, spread plate and membrane filter methods for heterotrophic counts.
The European Pharmacopoeia recommends in paragraph Water for Injections (Aqua ad iniectabilia) this medium for the microbial monitoring of this water during the process of production and storage in the preparation of medicines. It is also recommended for analysis of Water for preparations of extracts, water highly purified and water purified.
R2A AGAR was developed by Reasoner and Geldreich for bacteriological plate counts of treated potable water, being able to recover the stressed chlorine-treated bacteria. Nutritionally rich mediums suppress these slow growing bacteria, whereas a low nutrient medium, such as R2A Agar, in combination with a lower incubation temperature and longer incubation time, stimulates the growth of stressed and chlorine-tolerant bacteria.
Proteose peptone and Casein Hydrolysate provide nitrogen, vitamins, minerals and amino acids essential for growth. Yeast extract is the source of vitamins, particularly of the B-group. Dextrose is a source of fermentable carbohydrate as an energy source; Starch absorbs toxic metabolic byproducts and thereby aids the recovery of injured organisms. Sodium pyruvate increases the recovery of stressed cells. Magnesium sulfate provides divalent cations and sulfate. Dipotassium phosphate is used to balance the pH and provide phosphate. Bacteriological agar is solidifying base.
R2A Agar is recommended in Standard Methods for the Examination of Water and Wastewater for pour plate, spread plate and membrane filter methods for heterotrophic counts.
The European Pharmacopoeia recommends in paragraph Water for Injections (Aqua ad iniectabilia) this medium for the microbial monitoring of this water during the process of production and storage in the preparation of medicines. It is also recommended for analysis of Water for preparations of extracts, water highly purified and water purified.
| Brand | CONDALAB |
|---|
Write Your Own Review

Validate your login